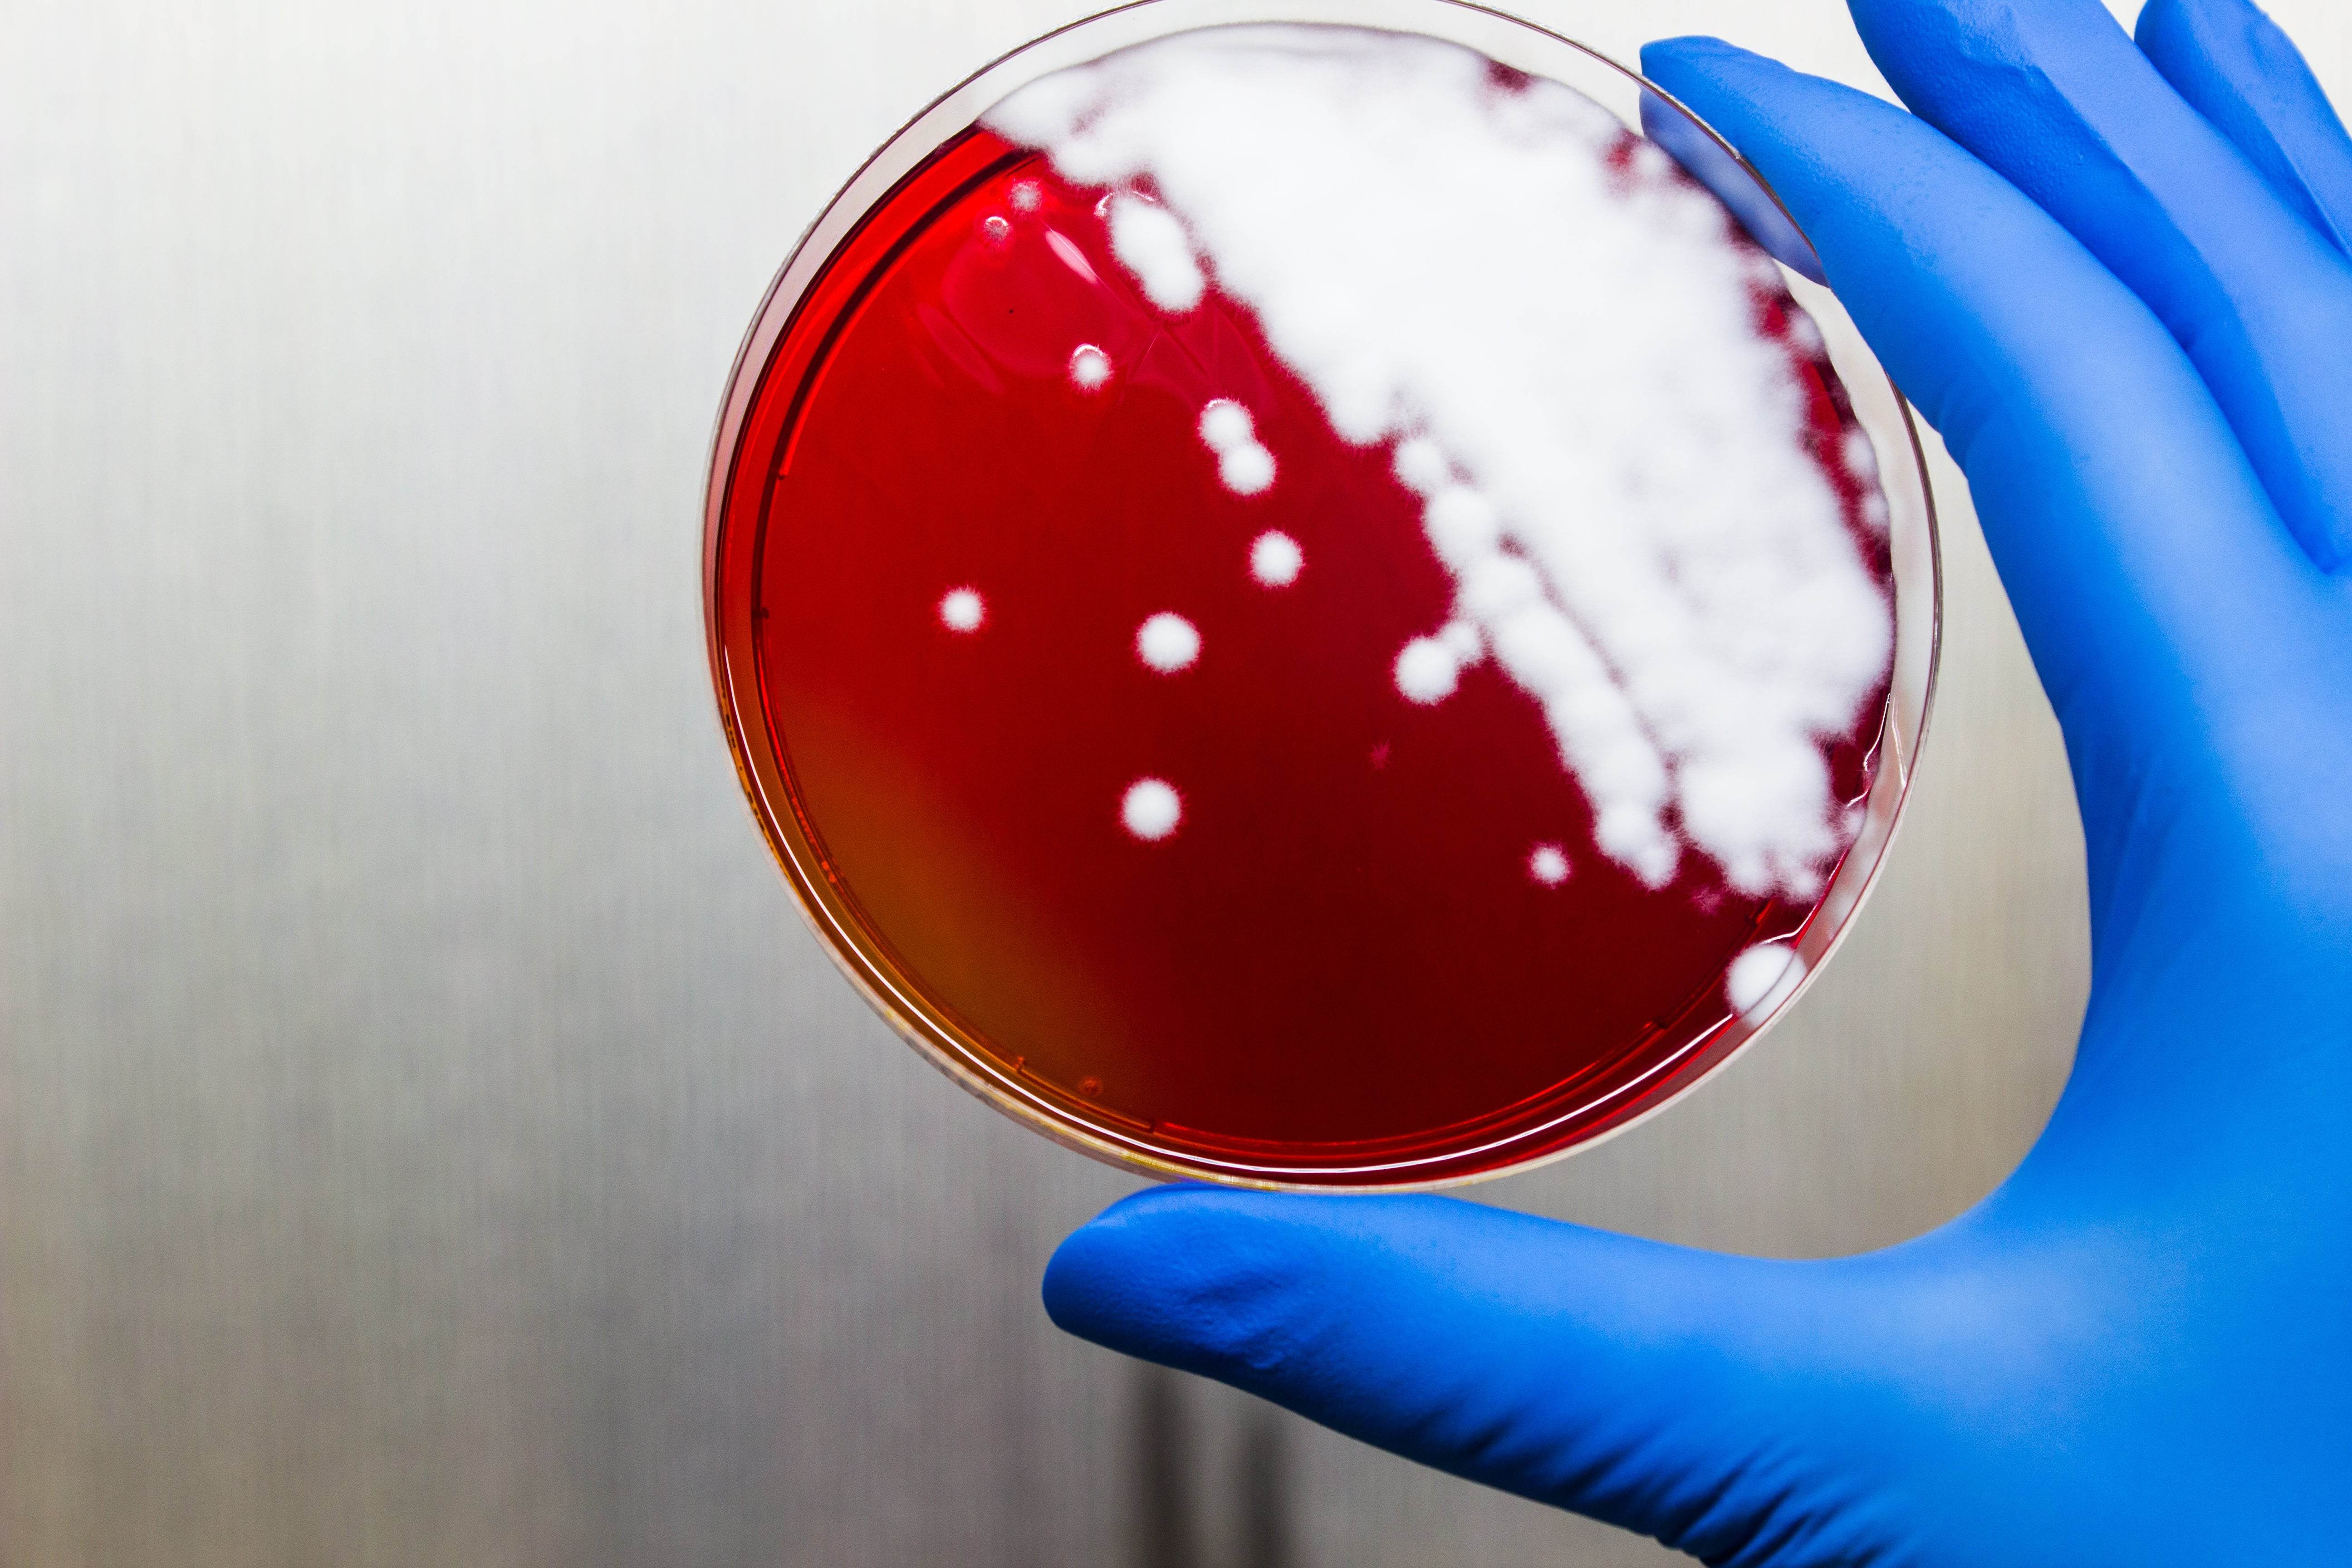
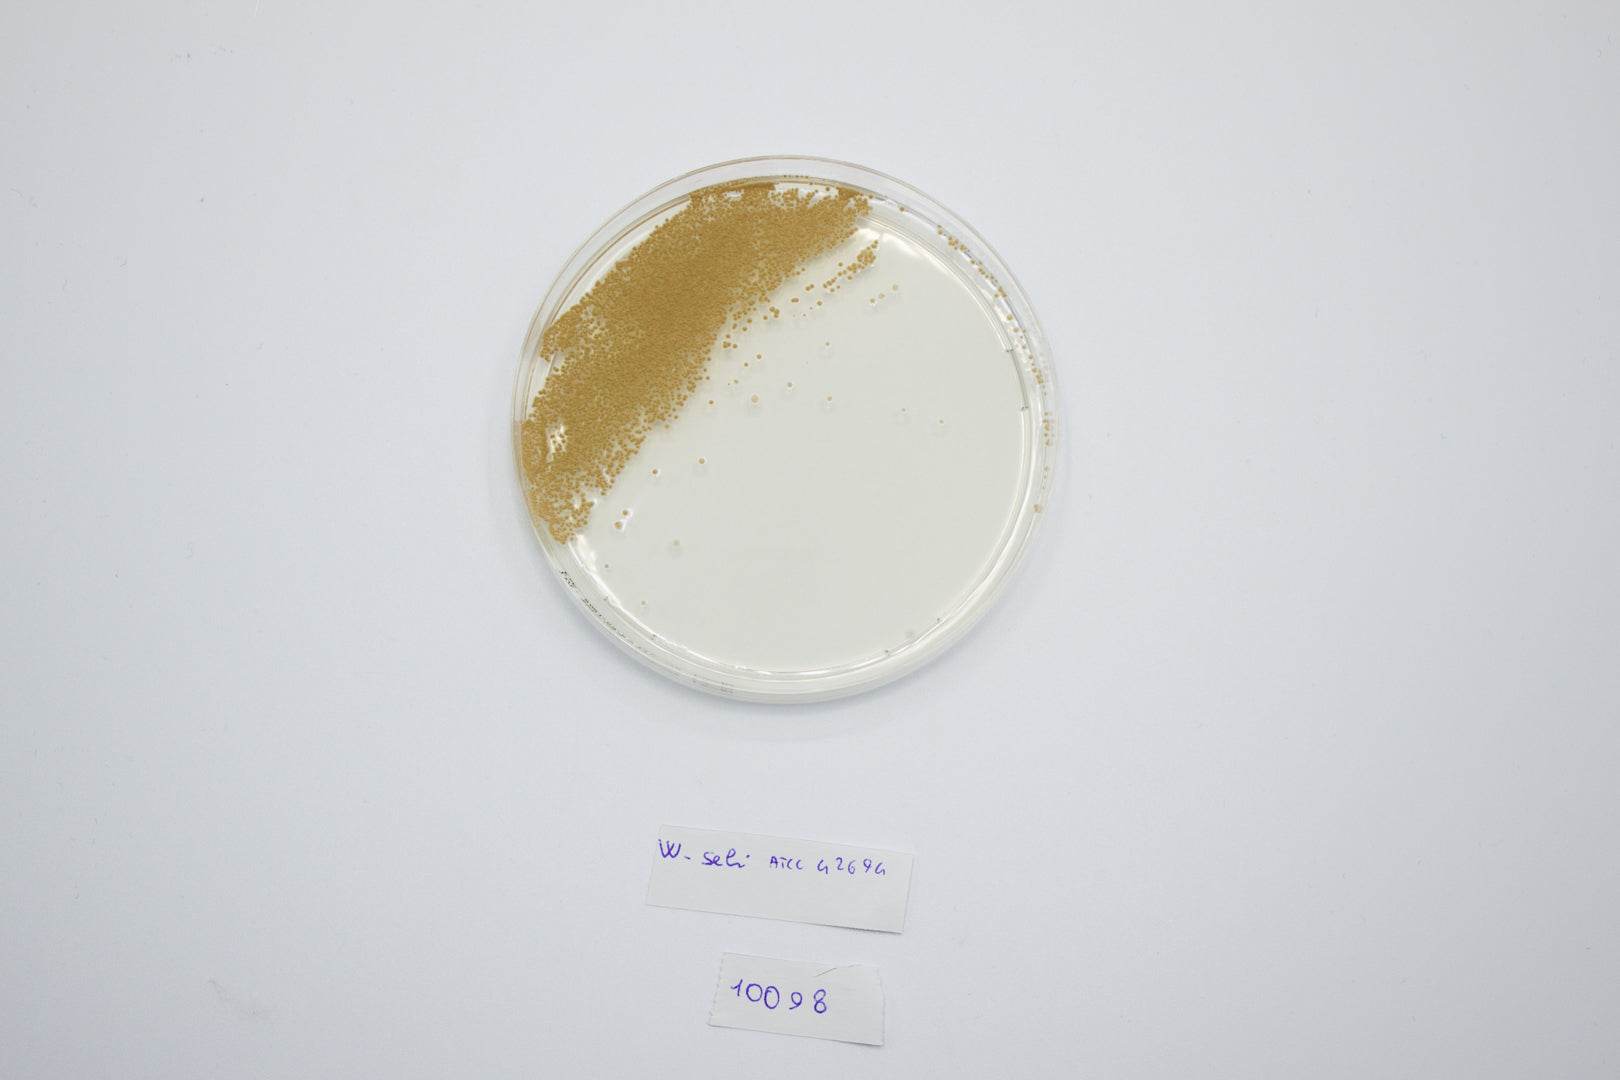
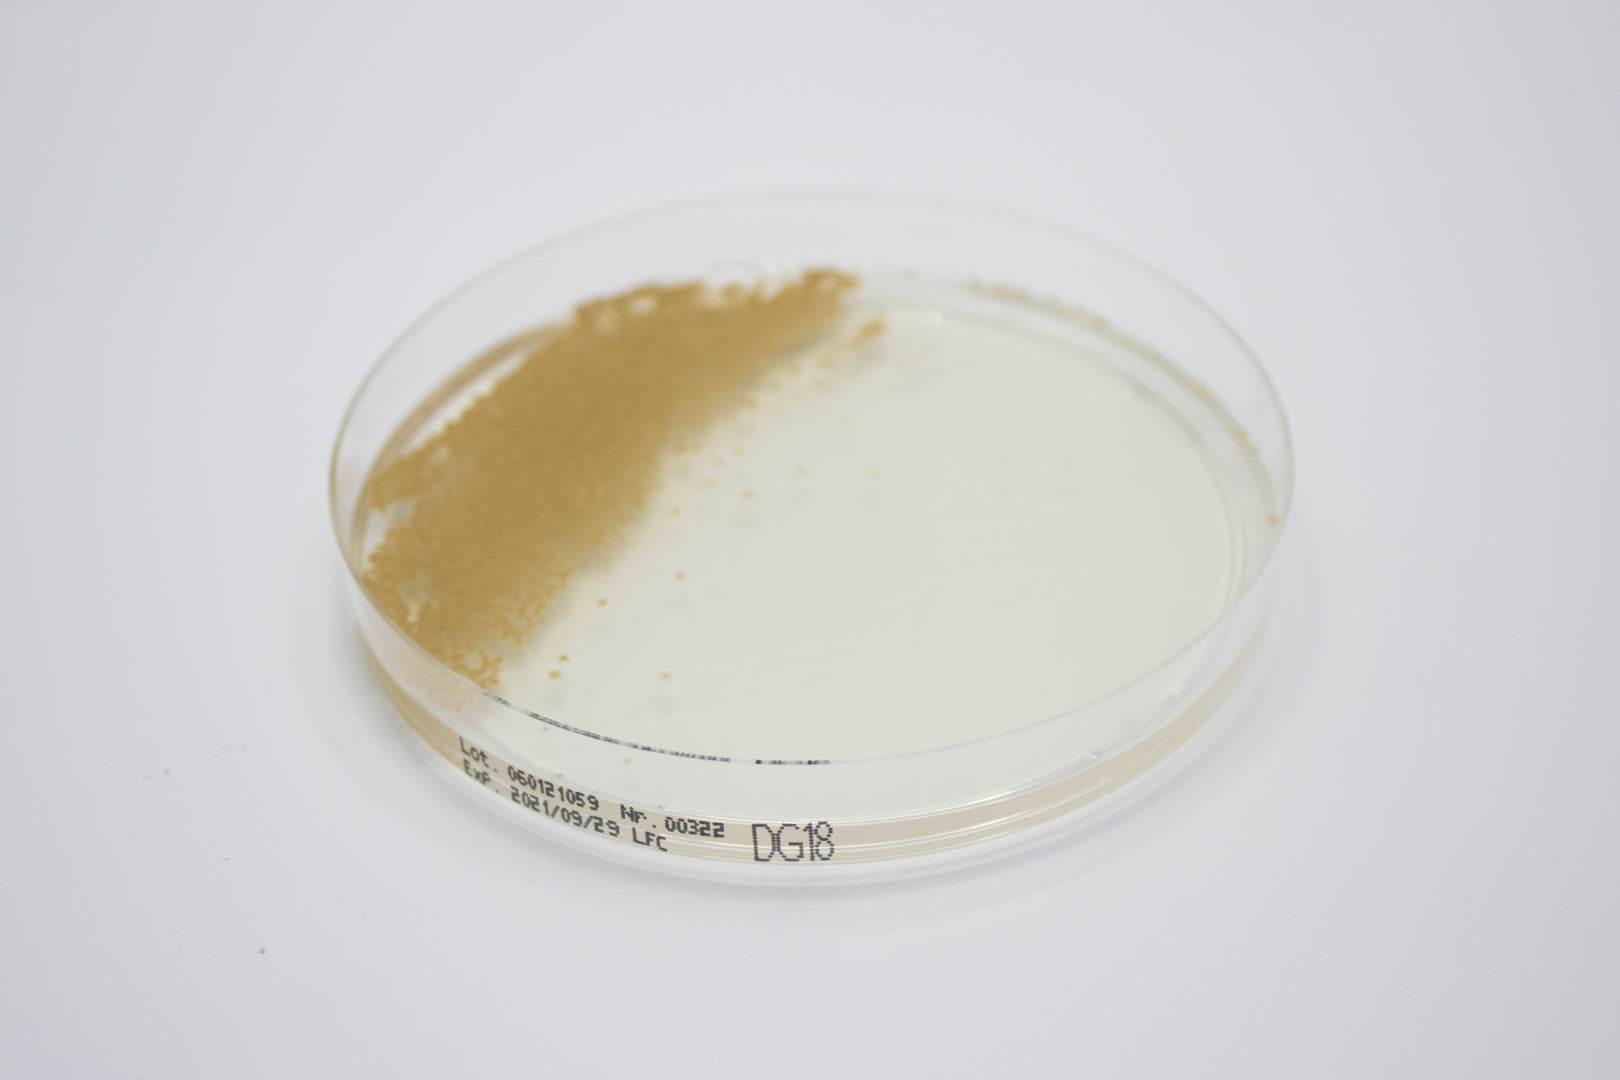

All Products
Showing 1321 - 1344 of 1448 products
Display
View


Liofilchem
Contact Slide 9 (PCA+TTC+Neutralizing x 2) - For Microbiology Lab Testing
Sale priceFrom $145.00 CAD


Liofilchem
Contact Slide TSA + NEUTR./ ROSE Bengal - For Microbiology Lab Testing
Sale priceFrom $145.00 CAD

Liofilchem
E.V.A. Broth (ETHYL Violet Azide) - For Microbiology Lab Testing
Sale priceFrom $91.00 CAD
Filters (0)